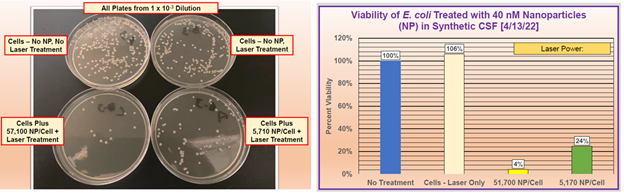
nugtbob11's tweet image. OTC Recap: $HALB Eliminates E. Coli in 20 Minutes vs. 7-10 Days.

accesswire.com/697767/halberd…

#OTCRecap #EColi

#otcrecap search results
OTC Recap: $MSCH MainStreetChamber Holdings Accelerates 100-Company Strategy with Eight Acquisitions, Including Disruptive Diamond Business and Insurance Platform Reinvention otcmarkets.com/stock/MSCH/new… #OTCRecap #Invest #Investment #Growth #Acquisitions #Diamond #Insurance
OTC Recap: $AMLM American Lithium Minerals, Inc. (OTC: AMLM) Completes Three Strategic Acquisitions of Gold, Silver, Copper and Rare Earth Elements Projects in Quebec prnewswire.com/news-releases/… #OTCRecap #Invest #Investment #Growth #Gold #Silver #Copper
OTC Recap: $BMXI Brookmount Gold Provides Earnings Guidance for the Full Year 2025 accessnewswire.com/newsroom/en/me… #OTCRecap #Invest #Investment #Growth #Gold #Earnings
OTC Recap: $MMCP Mag Mile Capital Closes $163.5 Million in Total Debt on Behalf of HKB Investment Group Structuring Additional $90 Million for 10 Hotel Assets Across Multiple States newsfilecorp.com/release/285888… #OTCRecap #Invest #Investment #Growth
OTC Recap: $BCBC Bitcoin Bancorp Launches Texas Deployment of Licensed Bitcoin ATM Network With First 50 ATM Installations globenewswire.com/news-release/2… #OTCRecap #Invest #Investment #Growth #Bitcoin #Crypto #ATM
OTC Recap: $RDTCF $DOSE.CN Rapid Dose Therapeutics (DOSE) (RDTCF) Secures Patent for QuickStrip(TM) Nicotine Oral Film Targeting $38B Smoke-Free Nicotine Market newsfilecorp.com/release/286365… #OTCRecap #Invest #Investment #Growth #Nicotine #Patent
OTC Recap: $MWAI MedWell Ai Reports Strong Q2 Revenues Of $548,315 And Provides Guidance For Full Year 2025 Exceeding $2,200,000. otcmarkets.com/stock/MWAI/new… #OTCRecap #Invest #Investment #Growth #AI #Revenue #Guidance
OTC Recap: $RDTCF $DOSE.CN Rapid Dose Therapeutics Advances Cannabinoid Research and Clinical Evaluation of QuickStrip(TM) Platform newsfilecorp.com/release/284877… #OTCRecap #Invest #Investment #Growth #Cannabinoid
OTC Recap: $BMXI Brookmount Gold Provides Update on Audit Status accessnewswire.com/newsroom/en/me… #OTCRecap #Invest #Investment #Growth #Gold #Audit
OTC Recap: $FAGI Qubee Hive Holdings, Inc. Completes Institutional KYC Approval with BitGo, Clearing Final Infrastructure Milestone Ahead of YAHBEE Wallet Launch accessnewswire.com/newsroom/en/bu… #OTCRecap #Invest #Investment #Growth #Milestone #Wallet
OTC Recap: $BRQL Dynamic Aerospace Systems (OTCQB: BRQL) Announces 3 New Provisional Patents to Add to Its Growing Patent IP Portfolio accessnewswire.com/newsroom/en/co… #OTCRecap #Invest #Investment #Growth #Aerospace #IP #Portfolio
OTC Recap: $XONI Xtreme One Entertainment Announces XFC’s Return to Iowa for Live MMA Event on April 25 with XFC 54: Ascension globenewswire.com/news-release/2… #OTCRecap #Invest #Investment #Growth #MMA #XFC
OTC Recap: $BMTM Big Village, A Bright Mountain Company, Joins Indie Agency News as Preferred Data and Insights Partner globenewswire.com/news-release/2… #OTCRecap #Invest #Investment #Growth #Partnership
OTC Recap: $AMLM American Lithium Minerals, Inc. (OTC: AMLM) Reports Fiscal Q1 2026 Results and Provides Update on Potentially Largest Lithium and Gold Discoveries in North America prnewswire.com/news-releases/… #OTCRecap #Invest #Investment #Growth #Financials #Gold #Lithium
OTC Recap: $CBDW 1606 Corp. (OTC:CBDW) Enters into Term Sheet to Acquire Texas 55 MW Power Generation Facility and 50,000 SQ Foot Data-Center Ready Climate Controlled Warehouse accessnewswire.com/newsroom/en/co… #OTCRecap #Invest #Investment #Growth #Acquisition #Texas
OTC Recap: $RDTCF $DOSE.CN Rapid Dose Therapeutics Launches QuickStrip(TM) Medical Cannabis for Patients in Brazil following ANVISA Approval of Sublingual and Buccal Formats for Medical Treatment newsfilecorp.com/release/283385… #OTCRecap #Invest #Investment #Growth #Medical #Cannabis
OTC Recap: $MWAI MedWell Ai Executes Letter Of Intent To Create America's First Vertically Integrated Regenerative Wellness Eco-System globenewswire.com/news-release/2… #OTCRecap #Invest #Investment #Growth #Wellness #AI
OTC Recap: $CSDX CS Group (OTCQB: CSDX) Appoints Shah Teelani & Associates, a Dubai-Based PCAOB Auditor, to Consolidate All 2025 Financial Statements for CSDX, CS Interpharm GT LLC and CS Diagnostics Pharma GmbH otcmarkets.com/stock/CSDX/new… #OTCRecap #Invest #Investment #Growth
OTC Recap: $BMXI Brookmount Shares Latest Update on North America Gold Transaction & Recapitalisation accessnewswire.com/newsroom/en/me… #OTCRecap #Invest #Investment #Growth #Gold
OTC Recap: $AMLM SEC Qualifies Company's Regulation A Offering for up to $20 Million prnewswire.com/news-releases/… #OTCRecap #Invest #Investment #Growth #RegA
prnewswire.com
SEC Qualifies Company's Regulation A Offering for up to $20 Million
/PRNewswire/ -- American Lithium Minerals Inc. (OTC: AMLM) ("AMLM" or the "Company") an exploration stage mining company focused on gold, silver, lithium, rare...
OTC Recap: $GTXO National Healthcare Agreement signed by GTX’s Swedish distributor, Posifon AB, to Supply GPS SmartSoles to Health Authorities and Municipalities. globenewswire.com/news-release/2… #OTCRecap

OTC Recap: $GEGR Announces Acquisition of Forty (40%) of GATE srl newsfilecorp.com/release/121008 #OTCRecap #Magazines

OTC Recap: $PBIO Presented at the Sequire Cannabis & Psychedelics Investor Conference. Get a replay from the link below: cannabis-conference22.mysequire.com #OTCRecap #Cannabis #Psychedlics

OTC Recap: $GEVI General Enterprise Ventures, Inc. Issues First Shareholder Update of 2022 accesswire.com/698162/general… #OTCRecap

OTC Recap: $NSAV has acquired the revolutionary WEB 3.0 Crypto Wallet, AWALLET. globenewswire.com/news-release/2… #OTCRecap

OTC Recap: $SWISF $SKUR Starts Sales in Colombia - Starting Latin America Expansion. accesswire.com/698121/sekur-p… #OTCRecap #Colombia #CyberSecurity

OTC Recap: $GTCH Filed Non-Provisional Patent Covering Media & Advertisement Domains Utilizing AI Technology. globenewswire.com/news-release/2… #OTCRecap

OTC Recap: $AITX Multiple ROSA Order from East Coast Private College. globenewswire.com/news-release/2… #OTCRecap #Robots #Robotics #College

OTC Recap: $SNRG Reports Fourth Quarter and Full Year 2021 Financial Results. newsfilecorp.com/release/120791 #OTCRecap

OTC Recap: $HALB Eliminates E. Coli in 20 Minutes vs. 7-10 Days. accesswire.com/697767/halberd… #OTCRecap #EColi
OTC Recap: $HNRC HNRC OUTLINES SPAC STRATEGY AND DIVIDEND POLICY prnewswire.com/news-releases/… #OTCRecap #SPAC

Something went wrong.
Something went wrong.
United States Trends
- 1. robby N/A
- 2. Shai N/A
- 3. #thepitt N/A
- 4. Langdon N/A
- 5. Jack Harlow N/A
- 6. Chet N/A
- 7. Whale - Buy N/A
- 8. 10m TXs N/A
- 9. Clemson N/A
- 10. Pritchard N/A
- 11. Samira N/A
- 12. garcia N/A
- 13. #ANTI_ANXIETY_CLUB N/A
- 14. Baron Corbin N/A
- 15. #7TH_YEAR N/A
- 16. Friday the 13th N/A
- 17. #kubball N/A
- 18. Hubert N/A
- 19. 5m TXs N/A
- 20. Jaylen Brown N/A




